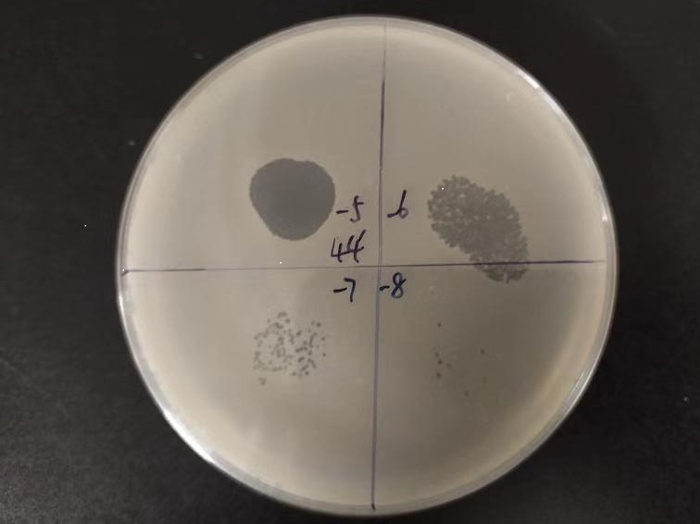

原标题:危害西红柿烟草的青枯病 最新研究找到了“靶向疗法”
新京报讯(记者 周怀宗)土传青枯病是西红柿、辣椒、烟草等数百种常见经济作物最主要的病害之一,在我国各省份几乎都有发现,影响作物上百种,最严重的情况,可能导致绝收。

患青枯病后枯死的西红柿。受访者供图
一直以来,传统的农药喷施、熏蒸等措施在阻控病害发生中发挥重要作用,但容易使病原菌产生耐药性,并且广谱杀菌手段在杀灭病原菌的同时,也杀灭了其他微生物,破坏了土壤生态,使反扑回来的有害菌更难被抑制。
近日,南京农业大学资源与环境科学学院沈其荣教授带领的土壤微生物与有机肥团队微生态与根际健康实验室,在利用噬菌体定向调控土壤菌群-防控土传青枯病领域取得重要进展。该成果揭示噬菌体不仅可以“专性猎杀”和“精准靶向”病原菌,降低其生存竞争能力;同时还能够重新调整根际土壤菌群的结构,恢复群落多样性,增加群落中拮抗有益菌的丰度。成果于12月3日凌晨零点发表在国际顶级学术期刊《自然生物技术》上。
噬菌体裂解细菌形成的噬菌斑。受访者供图
土壤环境恶化,土传病害频频发生
近年来,一些地区因为集约化农业的不合理措施,如化肥农药的持续过量投入以及经济作物的单一连作,导致土壤微生物群落结构严重失衡,生态功能急剧削弱。
“和人体一样,土壤中有大量微生物,这些微生物绝大部分对农作物是无害的,有一些还承担着一定的功能,比如养分周转、分解进入土壤的有害物质等。但也有一部分是有害的,可能导致农作物生病、死亡等。正常情况下,微生物之间也有相互制约的作用,在一定程度上维系着微生物群落的平衡,客观上也有保护农作物的作用,有效降低有害菌对农作物的危害”,论文共同第一作者韦中博士说。
土壤养分周转不畅、污染难以消解、土传病害频发就是土壤微生态失衡重要证据,这些也是农业资源与环境领域亟待解决的难题。“土壤不健康了,给作物供应再多养分也没有用。”沈其荣教授告诉记者。

患青枯病的西红柿。受访者供图
由青枯菌引起的土传青枯病,是团队中徐阳春教授和韦中博士负责的微生态与根际健康实验室重点关注的对象。
韦中博士介绍,“青枯菌在土壤中存活时间长,能够侵染番茄、茄子、辣椒、烟草、生姜、花生等400多种植物。青枯病是一种全球广泛流行的土传疾病,有调查显示,在我国,只有三四个省份没有报道过相关疾病,其他地方都有,100多种植物受它影响。我们曾经在一些地方见到青枯病导致整棚西红柿死亡的例子”。
从“化疗”到“靶向治疗”
治疗青枯病,传统的方法多是喷施农药或药物熏蒸,韦中介绍,化学农药和熏蒸等方法短期内见效快,但病原菌容易形成耐药性;再加上农药和熏蒸剂靶向性不强,在杀灭病原菌的同时也破坏了土壤正常的微生物群落,危及到土壤微生物的生态功能,很可能导致病原菌二次侵染时造成更大危害。
“就像‘化疗’一样,杀灭癌细胞,也杀灭了健康细胞。青枯病的传统治疗方式也类似,因为多使用广谱抗生素,针对性不强,杀灭青枯菌的同时,也会杀灭其他微生物,结果导致土壤微生态被破坏,微生物之间的制约性没有了,一旦病原菌传播,可能更难抑制”,韦中说,“土壤并不是任劳任怨的,看起来什么东西埋进去都能分解,其实不然。农药、化肥的长期使用,单一作物的长期种植等,都可能造成土壤微生态的紊乱,进而使得有害菌泛滥,难以控制”。
能否找到一种既能精准猎杀土壤病原菌,又不破坏土壤微生物群落结构和生态功能的环境友好型措施呢?这是可持续农业发展亟须的土传病害防控技术:“精准治疗+生态友好”。
“我们发现,土壤中噬菌体经过一定组合,可以显著降低根际病原青枯菌的数量”,韦中介绍说,“噬菌体是一类专性侵染细菌的病毒,有很多种,在环境中普遍存在。噬菌体对宿主细菌具有高度侵染特异性,可以实现对特定病原菌的精准裂解,并且能够动态压制病原菌数量。但单一种类的噬菌体对青枯菌的侵染并不显著,在经过一定组合之后,才开始变得高效,并且组合多样性越高,病原菌成功突变抵御噬菌体的概率越低。即便有一些青枯菌成功突变、残存了下来,但它们的生长显著减缓,这说明它们与土壤中其它微生物竞争的能力减弱,再次侵染作物根系的能力会下降”。

噬菌体鸡尾酒激发根际免疫的机制。受访者供图
和传统的“灭杀病原菌同时也灭杀其他细菌”的药物不同,噬菌体是土壤中原本就有的微生物,我们筛选的专性裂解噬菌体能够精准灭杀青枯菌,“就像是靶向治疗一样,只打靶子,不会误伤”,韦中说。
此外,研究发现,噬菌体组合灭杀青枯菌之后,还在一定程度上有恢复土壤微生态的作用。研究发现,病原青枯菌会导致土壤群落结构发生巨变,并且多样性显著下降。不过,这种影响可以被噬菌体修复,被破坏的微生物群落多样性可以恢复提升到原有水平。
“这就相当于,不仅找到了精确猎杀病原菌的‘狙击手’,同时还触发了根际免疫,让原先被打垮的根际菌群又组建了一支‘防御军团’,这将为应用推广噬菌体疗法作为精准靶控、生态安全的土传病害防治措施提供重要的理论依据”,沈其荣说。
新京报记者 周怀宗 编辑 唐峥
校对 李立军


